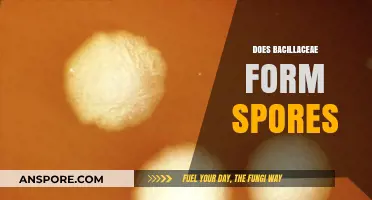
Bacillaceae Sporulation: Understanding How This Bacterial Family Forms Spores

Apple cider vinegar (ACV) is often touted as a natural remedy for various ailments, including skin conditions like ringworm. Ringworm, a fungal infection caused by dermatophytes, can be persistent due to its ability to leave behind spores that may lead to recurring infections. Many people wonder whether ACV, with its acidic and antimicrobial properties, can effectively kill ringworm spores. While ACV’s acetic acid content may inhibit fungal growth and create an unfavorable environment for spores, there is limited scientific evidence to conclusively prove its ability to eliminate ringworm spores entirely. As a result, while ACV may offer symptomatic relief or act as a complementary treatment, it is generally recommended to use proven antifungal medications for complete eradication of the infection and its spores.
| Characteristics | Values |
|---|---|
| Effectiveness Against Ringworm Spores | Limited scientific evidence directly confirming ACV's ability to kill ringworm spores. Some anecdotal reports suggest it may help due to its acidic nature, but this is not conclusive. |
| Mechanism of Action | ACV's acetic acid content (typically 5-6%) creates an acidic environment that may inhibit fungal growth, but its effectiveness against spores (which are more resistant) is uncertain. |
| Scientific Studies | Lack of peer-reviewed studies specifically investigating ACV's effect on ringworm spores. Most research focuses on its general antifungal properties against active infections, not spores. |
| Recommended Use | Not a proven treatment for ringworm spore eradication. May be used as a complementary approach alongside proven antifungal medications. |
| Safety | Generally safe for topical use when diluted, but can cause skin irritation. Not recommended for internal use to treat ringworm. |
| Alternatives | Proven antifungal treatments like topical creams (clotrimazole, miconazole) or oral medications (terbinafine) are more effective against ringworm and its spores. |
| Prevention | ACV may have some role in preventing fungal growth due to its acidity, but it's not a substitute for proper hygiene and environmental cleaning. |
Explore related products
What You'll Learn

ACV's antifungal properties against ringworm spores
Apple cider vinegar (ACV) has long been touted for its antimicrobial properties, but its effectiveness against ringworm spores specifically is a nuanced topic. Ringworm, caused by dermatophytes, thrives in warm, moist environments and can be stubborn to eradicate. ACV’s acetic acid content, typically around 5%, is believed to disrupt fungal cell membranes, potentially inhibiting growth. However, while anecdotal evidence supports its use, scientific studies on ACV’s direct impact on ringworm spores remain limited. This gap highlights the need for caution when relying solely on ACV as a treatment.
To use ACV against ringworm, dilute it with water in a 1:1 ratio to avoid skin irritation, especially in children or those with sensitive skin. Apply the solution directly to the affected area using a cotton ball, leaving it on for 15–20 minutes before rinsing. Repeat this process twice daily for at least two weeks. For scalp ringworm, consider adding a few drops of tea tree oil to enhance antifungal activity. However, monitor for redness or burning, as ACV’s acidity can exacerbate irritation if not properly diluted.
Comparatively, over-the-counter antifungal creams like clotrimazole or terbinafine are clinically proven to kill ringworm spores and are often more reliable. ACV may serve as a complementary treatment rather than a standalone solution. Its strength lies in its accessibility and affordability, making it a viable option for mild cases or as a preventive measure. However, severe or persistent infections warrant professional medical advice to avoid complications.
A descriptive approach reveals ACV’s application as a straightforward, natural remedy. Its clear, pungent liquid transforms into a soothing treatment when diluted, offering a gentle alternative to harsh chemicals. Users often report a tingling sensation upon application, which subsides as the solution dries. While not a miracle cure, ACV’s antifungal properties make it a practical addition to home remedies, particularly for those seeking non-pharmaceutical options. Always pair its use with good hygiene practices, such as keeping the affected area clean and dry, to maximize effectiveness.
Conifer Reproduction: Do They Use Spores or Seeds to Multiply?
You may want to see also

Effectiveness of ACV concentration on spore elimination
Apple cider vinegar (ACV) is often touted as a natural remedy for various ailments, including fungal infections like ringworm. However, its effectiveness in killing ringworm spores hinges significantly on concentration. Diluted ACV, typically around 5% acetic acid, is commonly used in household applications but may not possess the potency required to eliminate resilient fungal spores. Higher concentrations, such as 10% or more, are theorized to disrupt the spore’s cell membrane, potentially leading to their destruction. Yet, practical application of such concentrations raises concerns about skin irritation and safety, particularly for children or those with sensitive skin.
To explore the optimal ACV concentration for spore elimination, consider a stepwise approach. Start with a 5% solution, applying it topically to the affected area twice daily for at least one week. Monitor for improvements, such as reduced redness or itching. If no significant changes occur, gradually increase the concentration to 10% by mixing equal parts ACV and water. This dilution balances potency with skin safety, though patch testing is essential to avoid adverse reactions. For stubborn cases, a 15% solution may be attempted, but this should be reserved for short-term use under close observation.
Comparatively, commercial antifungal treatments often contain active ingredients like clotrimazole or terbinafine, which are specifically formulated to target fungal spores. While ACV’s natural acidity may offer a milder alternative, its efficacy at lower concentrations is questionable. Studies on ACV’s antifungal properties primarily focus on its ability to inhibit fungal growth rather than eradicate spores, suggesting that higher concentrations or prolonged exposure may be necessary for spore elimination. This highlights the importance of patience and consistency when using ACV as a treatment.
A critical takeaway is that ACV’s effectiveness against ringworm spores is concentration-dependent, but practicality and safety must guide its use. For instance, a 10% solution applied with a cotton ball for 15–20 minutes daily may yield better results than a weaker dilution. However, individuals with broken skin or pre-existing conditions should avoid high concentrations altogether. Combining ACV treatment with good hygiene practices, such as washing linens in hot water and avoiding shared personal items, can enhance its efficacy. Ultimately, while ACV shows promise, it may not replace conventional treatments for severe or persistent infections.
Do Gram-Negative Rods Form Spores? Unraveling Bacterial Survival Mechanisms
You may want to see also

ACV application methods for spore treatment
Apple cider vinegar (ACV) is often touted for its antifungal properties, making it a popular home remedy for treating ringworm. However, its effectiveness against ringworm spores specifically remains a topic of debate. While ACV’s acetic acid content can inhibit fungal growth, spores are notoriously resilient, requiring targeted application methods to maximize potential benefits. Here’s how to approach ACV application for spore treatment.
Direct Topical Application: For localized ringworm infections, dilute ACV with an equal amount of water to reduce skin irritation. Using a cotton ball, gently apply the solution to the affected area twice daily. Allow it to air dry; do not rinse. This method ensures prolonged contact between the acetic acid and the spores, potentially weakening their structure. Note: Test on a small skin area first to check for sensitivity, especially in children or those with eczema.
Soaking for Persistent Cases: For ringworm on the feet (tinea pedis) or nails, a soaking method may be more effective. Mix 1 part ACV with 2 parts warm water in a basin, and soak the affected area for 15–20 minutes daily. This approach helps penetrate thicker skin layers where spores may reside. For added efficacy, combine with antifungal powders or creams after drying the area thoroughly.
Environmental Disinfection: Ringworm spores can survive on surfaces, reinfecting individuals even after treatment. To disinfect, use undiluted ACV in a spray bottle to treat contaminated items like combs, clothing, or pet bedding. Let it sit for 10–15 minutes before wiping clean. This method leverages ACV’s acidity to disrupt spore viability, reducing the risk of recurrence.
While ACV shows promise as an adjunct treatment, it should not replace prescription antifungals for severe or persistent infections. Its application methods, when used consistently and correctly, may aid in managing ringworm and minimizing spore survival. However, consult a healthcare provider if symptoms worsen or persist beyond two weeks.
Can Dehydrated Morel Spores Still Grow Mushrooms? Viability Explored
You may want to see also
Explore related products

Scientific studies on ACV and ringworm spores
Apple cider vinegar (ACV) is often touted as a natural remedy for various ailments, including fungal infections like ringworm. However, scientific studies specifically addressing its efficacy against ringworm spores are limited. Ringworm, caused by dermatophytes, relies on spores for survival and transmission, making their eradication crucial for treatment. While anecdotal evidence supports ACV’s antifungal properties, rigorous research is sparse. Most studies focus on ACV’s general antimicrobial activity rather than its targeted effect on ringworm spores. This gap highlights the need for controlled trials to validate its use.
One study published in the *Journal of Prosthodontics* (2014) examined ACV’s antifungal activity against *Candida* species, a different fungus, and found it effective at concentrations of 4% to 6%. While this suggests potential against fungi, ringworm spores are structurally and chemically distinct, requiring higher resilience to environmental stressors. Another study in *Evidence-Based Complementary and Alternative Medicine* (2018) explored ACV’s acetic acid content, noting its ability to disrupt fungal cell membranes. However, the study did not test ringworm spores directly, leaving questions about its applicability.
Practical application of ACV for ringworm often involves diluting it with water (1:1 ratio) and applying it topically twice daily. For children or sensitive skin, further dilution (1:3 ratio) is advised. While this approach is widely shared in natural health circles, its effectiveness against spores remains unproven. Without scientific confirmation, relying solely on ACV could delay proper treatment, as over-the-counter antifungals like clotrimazole are proven to target both active infections and spores.
Comparatively, conventional treatments undergo extensive testing to ensure they penetrate fungal cells and neutralize spores. ACV’s lack of standardization in concentration and application methods adds variability, making it difficult to draw definitive conclusions. Until targeted studies emerge, ACV should be considered a complementary, not primary, option for ringworm. Its use is best paired with evidence-based treatments, especially for severe or persistent cases.
In summary, while ACV shows promise as an antifungal agent, its specific impact on ringworm spores remains scientifically unverified. Anecdotal success stories and studies on related fungi provide a foundation for interest but fall short of conclusive evidence. For those considering ACV, cautious, diluted application is recommended, but professional medical advice should always guide treatment decisions. The scientific community’s focus on this gap could offer clarity and safer, more effective natural alternatives in the future.
Freezing Spore Syringes: Preservation Tips and Best Practices
You may want to see also

Potential risks of using ACV on spores
Apple cider vinegar (ACV) is often touted as a natural remedy for various ailments, including ringworm. However, its effectiveness against ringworm spores remains scientifically unproven. While ACV’s acidic nature may inhibit fungal growth, spores are notoriously resilient, and relying solely on ACV could allow the infection to persist or worsen. This raises concerns about potential risks when using ACV as a treatment.
One significant risk is skin irritation or chemical burns, especially when ACV is applied undiluted. Its acetic acid content (typically 5-6%) can disrupt the skin’s pH balance, leading to redness, itching, or blistering, particularly in sensitive areas like the face, groin, or scalp. For children or individuals with eczema, the risk is amplified. Diluting ACV with water (1:1 ratio) reduces this risk but does not eliminate it entirely. Always perform a patch test before widespread application.
Another concern is delayed or ineffective treatment. Ringworm spores require antifungal agents to be eradicated, and ACV’s antifungal properties are inconsistent. Prolonged reliance on ACV may allow the infection to spread or become more resistant to conventional treatments. For instance, tinea capitis (scalp ringworm) often requires oral antifungals, and using ACV as a substitute could lead to hair loss or scarring. Consult a healthcare provider if symptoms persist after 2-3 days of home treatment.
Lastly, interactions with medications or pre-existing conditions cannot be overlooked. ACV can lower potassium levels or interact with diuretics, insulin, or laxatives, posing risks for individuals with diabetes, heart disease, or kidney issues. Topical use may seem harmless, but systemic absorption is possible, especially in open wounds or inflamed skin. Pregnant or breastfeeding individuals should avoid ACV due to insufficient safety data.
In summary, while ACV may offer mild antifungal benefits, its risks—skin irritation, treatment delays, and health interactions—outweigh its unproven efficacy against ringworm spores. For spore eradication, opt for proven antifungal creams (e.g., clotrimazole) or consult a healthcare professional. ACV can complement treatment (e.g., diluted soaks for itching) but should never replace it. Always prioritize evidence-based care over anecdotal remedies.
Understanding Spores: Biology's Tiny Survival Masters Explained Simply
You may want to see also
Frequently asked questions
Apple cider vinegar has antifungal properties that may help combat ringworm, but there is limited scientific evidence to confirm it kills spores directly.
Dilute apple cider vinegar with water (1:1 ratio) and apply it to the affected area using a cotton ball, leaving it on for 15–20 minutes before rinsing.
While it may help reduce fungal growth, apple cider vinegar is not a guaranteed method to eliminate ringworm spores on surfaces; disinfectants are more effective.
Undiluted apple cider vinegar can cause skin irritation or burns. Always dilute it and test a small area first; consult a healthcare provider for severe or persistent cases.